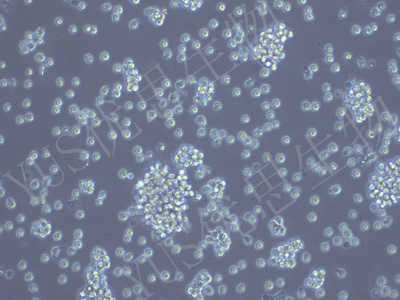
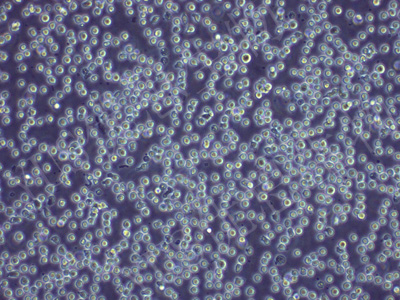

产品中心
产品中心
-

EB-3 人Burkitt's淋巴瘤细胞(STR鉴定)
货号:YLH656规格: 1*10^6 -

Hce-8693 人盲肠腺癌细胞(未分化)(STR鉴定)
货号:YLH657规格: 1*10^6 -

RKO-AS45-1 人结肠癌转基因细胞(STR鉴定)
货号:YLH658规格: 1*10^6 -

RKO-E6 人结肠癌转基因细胞(STR鉴定)
货号:YLH659规格: 1*10^6 -
JVM-2 EB病毒感染的人外周淋巴细胞(STR鉴定)
货号:YLH660规格: 1*10^6 -
JM 人T淋巴细胞白血病细胞(STR鉴定)
货号:YLH661规格: 1*10^6 -

BC-3 人淋巴瘤细胞(STR鉴定)
货号:YLH664规格: 1*10^6 -

ST486 人Burkitt's淋巴瘤细胞(STR鉴定)
货号:YLH668规格: 1*10^6 -

C99 人结肠癌腺癌细胞(STR鉴定)
货号:YLH674规格: 1*10^6 -

CCK-81 人结肠癌腺癌细胞(STR鉴定)
货号:YLH675规格: 1*10^6 -

HCC2935 人肺癌腺癌细胞(STR鉴定)
货号:YLH676规格: 1*10^6 -

LIM1215 人结直肠癌细胞(STR鉴定)
货号:YLH677规格: 1*10^6
在线咨询
Online consultation

关注微信公众号


